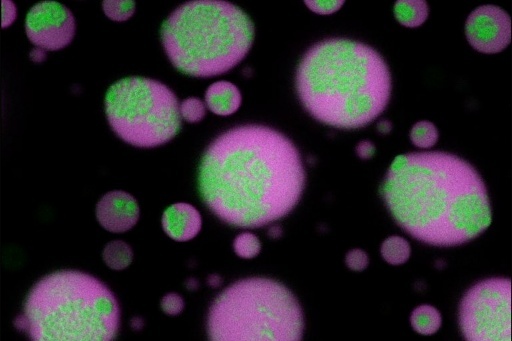

§ɦṛɛɗɗịɛ ßịⱺ𝔩ⱺɠịᵴŧ
“I would rather have questions that can’t be answered than answers that can’t be questioned.” – Rich Feynman
- 43 Posts
- 4 Comments

 1·1 month ago
1·1 month agoYep, cellulose is a beta pleated sheet, unlike carbs/sugars, which are alpha helices. We’re always ready to breakdown the alpha helices form of sugar, but due to the molecular structure of cellulose, we need help. This is were these enzymes come in from our microbiome. All this also ties into how in Western countries, most folks tend to be unable to breakdown cellulose due to the lack of the specific bacteria in our biome capable of producing this enzyme. However, in African and Asian countries, these bacteria are common place, so these cultures have been able to digest cellulose for ages!

 2·2 months ago
2·2 months agoWhile Nebula is a creator‑owned ad‑free video service, it’s truly just a conventional centrally‑hosted platform collecting user data like most sites. So while ad‑free, it has no focus on privacy as its privacy policy shows standard analytics and tracking typical of most subscription services. This being the case, it’s not a privacy respecting alternative to YouTube like Peer Tube much at all unfortunately.

 1·2 months ago
1·2 months agoWell said!!

SoundCloud is pretty cool, especially when compared to Spotify. I’ve been really liking the https://sc.maid.zone/ SoundCloud frontend recently, makes it more private and you can download the songs on the same page you can listen to them. But all in all, it really just comes down to your opinion regarding if you should talk positively about it.